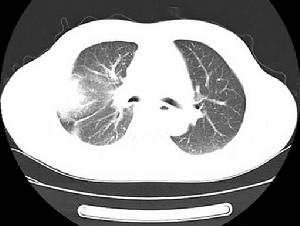
癌痛

症狀體徵
(一)全方位疼痛
 癌性疼痛表現
癌性疼痛表現癌症病人有時描述他們一生是痛苦的。因此,如果疼痛就要準備緩解時,照顧病人的那些人必需講出不適和苦惱的所有方面,雖然醫生可能有能力區別"生命的疼痛"各個區域,但病人經常卻不能--對他來說,這疼痛是全方位的,和包括所有一切的。
如果疼痛傳達消極信息,疼痛強度就增加。因之,只是一種背部疼且對可待因是有反應的疼痛,但當發現其原因是轉移癌時就需要嗎啡了、進而,疼痛持續了幾個月的病人是焦急的,因為他們考察未來和預期的只是持續和日益增加的疼痛。新發生的或惡化的疼痛暗示著疾病的進一步惡化--即更接近死亡的階段。
(二)勢不可擋的疼痛
在數周或數月疼痛之後,特別是伴有失眠時,很多癌症病人被疼痛制服,疼痛籠罩著他們整個精神視野,這樣的病人經常感到很難精確地描繪出疼痛的部位或性質。
(三)伴有強烈的植物神經異常
在大多數病人中,對持續疼痛的反應是植物神經性的,病人精神上和體力上都是退卻的,而且看起來是抑鬱的。有些病人焦慮占優勢,或焦慮與憂鬱混合在一起同時存在。在所有勢不可擋疼痛的病例中,存在“失眠→疲乏→疼痛→失眠”這樣的惡性循環。
(四)伴有心理學異常
在診斷時應進行心理學評價和初始的心理學的支持。當焦慮突出時,治療應包括鎮痛劑和抗焦慮劑,每種藥物的選擇和劑量,在很大程度上決定於病人以前服用過什麼藥。勢不可擋的疼痛伴有明顯焦慮最好看作是個緊急情況,需要大量時間對其進行治療。理想的是,在開始的幾天應該由一位有經驗的醫生負責醫學治療的各個方面,以便與病人及家屬建立一個良好的工作關係。可能既有明顯焦慮又有疼痛,而疼痛並不是勢不可擋的。當疼痛緩解時,中等程度的焦慮通常也會減輕,病人講出恐懼和擔心。
(五)伴體軀體化症狀
 癌性疼痛影像
癌性疼痛影像(六)痛苦與疼痛同時存在
疼痛和痛苦並不完全等同,因此,痛苦必須要與疼痛及可能與之相關聯的其他症狀相區別。病人可以耐受嚴重的疼痛而不考慮他們自己要道受的痛苦,如果他們知道,疼痛有一個確定的原因,疼痛是可以對付的。疼痛將是比較短暫的。另一方面,如果病人們相信或知道以下幾點,即使比較輕微的一些症狀也可以引起痛苦,這些症狀具有威脅生命的原因,它們是難治的,它們反映無希望的預後。
癌症對病人的影響通常是破壞性的,痛苦既可由疾病也可由其治療引起,痛苦不僅限於軀體症狀。為了確定痛苦的根源.需要從心理學上評價病人並提問未解決的問題。痛苦擴展到對社會及私人生活各方面的威脅。經受著疾病和治療對的外貌及各種能力影響兩方面的痛苦,以及病人對未來理解的痛苦。
(七)社會性疼痛
社會性疼痛的意思是與預期或實際的分離,或丟失有關的痛苦。癌症病人意識到他們將要因死亡而和家屬離別。因此,採取一些措施以避免使晚期重病人與他們的親友分離的一切事情是很重要的。允許病人孫兒、子女們探視,比增加阿片類的劑量更可以使其疼痛緩解得更好些。
(八)精神性疼痛
癌症的疼痛一直不斷。這個痛苦及死亡的前景造成了巨大的憂慮及不安,在姑息治療中,任何一個人或一種治療的作用一般都不這么激動人心。然而基本要旨仍末改變,也就是說癌症疼痛是一種軀體精神的感受,非軀體的各個方面必須要提出來。
癌性內臟痛的特點:
 癌性疼痛醫療儀器
癌性疼痛醫療儀器②疼痛常伴有其他部位的牽涉痛;
③疼痛部位大多不太明確,範圍較廣泛;
④疼痛常可引發較強的自主神經反射和骨骼肌痙攣。
另外,當腫瘤病人腫瘤部位出現疼痛或其他部位有疼痛時,首要的問題是明確疼痛是否由腫瘤引起:
1.乳腺癌原發腫瘤部位的炎症反應、胸臂的局部浸潤、腫瘤破潰及破潰後感染都可出現疼痛。腋窩轉移致淋巴回流受阻,手術損傷腋淋巴系統都可引起手、臂、肩及背部的腫脹疼痛。乳癌骨轉移或其他臟器轉移都可引起相應部位疼痛。骨轉移引起高血鈣可誘發腹痛。
2.肺癌肺癌早期可出現四肢關節疼痛。肺癌侵及胸膜可引起胸痛,骨轉移引起骨痛,顱腦轉移引起頭痛,肺尖部癌瘤侵及或壓迫臂叢神經或交感神經。可出現嚴重的肩、臂痛和Horner綜合徵。
3.胃腸癌胃癌可出胃痛。胃癌及腸道腫瘤出現肝或腹腔淋巴轉移,可出現腹及腰背痛。腸道腫瘤出現局部潰瘍、炎症可有腹部疼痛伴大便異常。腸道梗死可引起腸絞痛。如病人出現日益加重的持續性腹痛,應首先考慮惡性腫瘤的可能性。胃腸道腫瘤多見於老年人,其主要症狀是經常便血和並發貧血,往往影響正常的循環功能,誘發心絞痛或間歇性跛行,或因腸系膜缺血出現腸絞痛。胃腸手術後發生腸梗阻、腸粘連,也可出現腹部疼痛。
4.食管癌食管癌患者因局部潰瘍、炎症可出現胸骨後燒灼性疼痛,伴有進食阻擋感,偶可出現胸背痛。食管癌放射治療後,可因放射損傷引起胸背部放射性疼痛,此種疼痛與進食無明顯關係。
5.腦瘤長期頭痛伴有噁心、嘔吐或彎腰時因顱內壓增高使頭痛加劇,應考慮腦瘤的可能,腦瘤放療後出現腦水腫,也可引起頭痛。
6.其他宮頸、宮體癌可出現會陰部及大腿內側疼痛。口腔腫瘤可引起口腔、耳根部疼痛。
疾病病因
癌性疼痛X線圖
癌性疼痛X線圖1.腫瘤直接引起的疼痛
(1)組織毀壞:當腫瘤侵及胸膜、腹膜或神經,侵及骨膜或骨髓腔使其壓力增高甚至發生病理性骨折時,病人可出現疼痛,如骨轉移、骨腫瘤所致的骨痛。肺癌侵及胸膜可致胸痛。肺尖部腫瘤侵及臂叢可出現肩臂疼痛等。
(2)壓迫:腦腫瘤可引起頭痛及腦神經痛。鼻咽癌頸部轉移可壓迫臂神經叢或頸神經叢,引起頸、肩、臂痛。腹膜後腫瘤壓迫腰、腹神經叢,可引起腰、腹疼痛。神經組織受腫瘤壓迫常常同時並存神經受侵蝕。
(3)阻塞:空腔臟器被腫瘤阻塞時,可出現不適、痙攣,完全阻塞時可出現劇烈絞痛,如胃、腸及胰頭癌等。另外,乳腺癌腋窩淋巴結轉移時,可壓迫腋淋巴及血管引起患肢手臂腫脹疼痛。
(4)張力:原發及肝轉移腫瘤生長迅速時,肝包膜被過度伸展、繃緊便可出現右上腹劇烈脹痛。
(5)腫瘤潰爛,經久不愈,發生感染可引起劇痛。
2.腫瘤治療中引起的疼痛此種疼痛是癌症治療的常見併發症。
如放射性神經炎、口腔炎、皮膚炎,放射性骨壞死。放療、化療後可出現帶狀皰疹產生疼痛。化療藥物滲漏出血管外引起組織壞死,化療引起的栓塞性靜脈炎,中毒性周圍神經炎(長春鹼)乳腺癌根治術中損傷腋淋巴系統,可引起手臂腫脹疼痛。手術後切口瘢痕、神經損傷、幻肢痛。
3.腫瘤間接引起的疼痛衰竭病人的褥瘡,機體免疫力低下均可引起局部感染而產生疼痛。另外,前列腺、肺、乳腺、甲狀腺癌等出現骨轉移而引起劇烈的腹痛。
病理生理
 治療藥物
治療藥物內臟感覺的傳入通路基本上與軀體一致,但纖維占多數為80%。內臟的痛閾較高,對膨脹、痙攣、缺血性強直收縮和化學刺激較敏感(常引起劇烈疼痛,多伴有呼吸、血壓變化,以及出汗、豎毛、嘔吐、肌緊張增強等反應);另外,一個臟器的傳入纖維常常經幾個節段的脊神經進入中樞,而一個節段的脊神經又可包括幾個臟器的傳入纖維。例如,胃傳入節段包括胸6~9,與肝、膽、胰、脾、十二指腸等重疊。因而疼痛常較彌散而難以準確定位。內臟的神經支配是雙重的,痛覺衝動主要由交感神經傳入,盆腔臟器由骶部副交感神經傳入,氣管和食管上部由腦神經(舌咽神經和迷走神經)傳入。另外,內臟疼痛還有牽涉痛,可能是由內臟傳入衝動與軀體傳入的二通路在同節的脊髓背角細胞中發生聚合,相互作用,再由同一的傳導通路傳至大腦皮質;以致使疼痛定位發生偏差進而反映到軀體傳入所屬脊神經支配的皮膚區。例如,膽囊疼痛可反射到右側背部肩胛角下,胰腺疼痛可放射到腰背部等。
放射治療可引起放射性神經炎,出現疼痛。一致認為:當大劑量(幾千至上萬rad)放射線照射時,神經系統特別是神經元可出現直接損傷,並可引起繼發性神經損傷。這種損傷主要是放射線引起神經血液循環和營養障礙所致。電鏡下可見嚴重的血管內皮、血管壁基膜損傷,有時可見小血管阻塞或半阻塞。由於血液循環不良可引起小血管周圍膠質細胞神經突觸水腫,這樣運送給神經元細胞的養分就會不足或中止,水腫的膠質細胞突觸壓迫小血管,促使微循環更趨不良,由此形成惡性循環,如治療不及時或不適當,可導致神經元細胞死亡。在神經纖維發生炎症、水腫及壞死的過程中可出現疼痛。這种放射反應,有時還會出現延遲效應,幾周內,急性期的炎症、水腫、出血可逐漸消退,白質損傷可部分修復,但壞死仍殘留。以至在6~8周后又可再次出現症狀,有晚期放射性壞死之稱。照射劑量越大反應出現越快。
診斷檢查
 癌性疼痛確診
癌性疼痛確診1.疼痛的部位要求病人用手指出疼痛的部位。
2.疼痛的性質這樣可以明確內臟痛還是軀體痛。
軀體痛:一般表現為急性或慢性,痛的部位明確,性質為針刺樣痛、跳痛、刀割樣痛等。常見癌組織壓迫或侵及鄰近的軟組織、血管或骨等。
內臟痛:發病因素源於胸、腹、內臟器官,定位不明確,常伴有自主神經功能紊亂,如大汗淋漓等。性質為急慢性鈍痛、絞痛、脹痛等,可放射到遠處的體表即牽涉痛,常伴有各系統症狀。常見於癌腫壓迫血管、神經、筋膜、腸管引起臟器缺血,侵及胸、腹膜,肝、胰轉移引起包膜緊張等。
神經痛:由於外因及中樞神經受到損傷引起,性質為持續鈍痛伴短暫、嚴重的燒灼或觸電樣感覺異常,如皮膚麻木、針刺或蟻感,可有神經功能障礙。
暴發性痛:病人突然出現劇烈不可忍受的疼痛,並伴有其他症狀,常見如肝癌破裂、胃腸穿孔和臟器扭轉等。
3.疼痛的程度讓病人自己用語言表達輕度、中度及重度痛。
4.影響疼痛程度的因素如胸膜受侵時,咳嗽會使疼痛加劇;骨轉移病人,活動及壓迫時疼痛加劇;消化系統受侵時,會影響病人進食或進食時疼痛加劇。
5.了解病人疼痛對日常生活影響情況如飲食、睡眠、日常活動受干擾情況,以及接受止痛治療後疼痛緩解情況。
6.了解病人的既往史尤其對綜合醫院接受的病人,醫生往往會忽略病人的腫瘤病史,以免腫瘤病人使用應禁忌的治療方法,如對腫瘤部位進行理療、針灸及封閉等,這樣加劇疼痛,還會促進腫瘤的轉移。
7.了解疼痛與腫瘤發病的時間關係這樣可排除腫瘤原因,有利於鑑別診斷,如長年的風濕、類風濕、痛風等。
8.了解與抗腫瘤治療的時間關係這會幫助了解疼痛是腫瘤引起還是抗腫瘤治療的副作用引起。通過病人的主訴以獲得第一手資料,儘早發現病情發展情況,了解疼痛原因。另外,這也是對病人的一種精神安慰,能起到心理治療作用。體格檢查很重要,這樣可發現某些疼痛原因,如腫瘤、褥瘡、皮膚壞死等。了解病史及物理檢查以後,要藉助現代儀器對癌性疼痛原因進行確診。應當注意的是:檢查結果為陰性並不等於病人沒有腫瘤復發或轉移,也不能因此而否認病人有疼痛。總之,腫瘤病人出現疼痛首先考慮腫瘤原因。
實驗室檢查:可進行血常規、血生化等檢查。骨轉移時,血生化檢查發現高血鈣。
其他輔助檢查:CT、B超、核素、MRI、X線等有助於確定腫瘤的部位及性質。核素檢查對骨轉移可較早地提供明確診斷。
鑑別診斷:應與非腫瘤性的原發性疼痛相鑑別,需要根據病史及影像學檢查來確定。治療方案
 癌性疼痛檢查
癌性疼痛檢查1.藥物治療
(1)癌性疼痛的藥物治療原則:
①儘量口服給藥,便於長期用藥,可以減少依賴性和成癮性。
②有規律按時給藥,而不是出現疼痛時再給藥。
③按階梯給藥,根據WHO推薦的癌性疼痛“三階梯療法”。
④用藥應該個體化。
⑤注意使用抗焦慮、抗抑鬱和激素等輔助藥物,可提高鎮痛治療效果。
(2)癌性疼痛藥物治療的“三階梯療法”:
①第一階梯——非阿片類鎮痛藥:用於輕度癌性疼痛患者,主要藥物有阿司匹林、對乙醯氨基酚(撲熱息痛)等,可酌情套用輔助藥物。
②第二階梯——弱阿片類鎮痛藥:用於當非阿片類鎮痛藥不能滿意止痛時或中度癌性疼痛患者,主要藥物有可待因,一般建議與第一階梯藥物合用,因為兩類藥物作用機制不同,第一階梯藥物主要作用於外周神經系統,第二階梯藥物主要作用於中樞神經系統,二者合用可增強鎮痛效果。根據需要也可以使用輔助藥。
③第三階梯——強阿片類鎮痛藥:用於治療中度或重度癌性疼痛,當第一階梯和第二階梯藥物療效差時使用,主要藥物為嗎啡,也可酌情套用輔助藥物。
2.外科治療
(1)脊髓後正中後索點狀切開術(PMM):動物實驗和屍體神經解剖均證實:內臟痛覺的上行傳導通路很大部分是經由脊髓背柱上行的,特別是對於盆腔和下腹部的內臟痛覺傳導,脊髓背柱的作用甚至要超過脊髓丘腦束。PMM正是選擇性切斷了脊髓背柱中間部傳導內臟痛覺的神經纖維。1997年,美國Nauta等最先報導1例胸8PMM手術,治療子宮頸癌晚期頑固性盆腔和下腹部內臟痛,療效確切。1999年,德國Becker等也報導1例肺癌術後出現上腹部和中腹部疼痛,胸4PMM可以明顯緩解疼痛症狀。2000年,韓國KimYS等報導成功施行胸1~2節段PMM8例,均為胃癌引起的腹部內臟痛,止痛效果肯定。
(2)脊髓止痛手術:根據癌性內臟痛的不同部位和特點,考慮行脊神經後根切斷術、脊髓前外側束切斷術和脊髓前聯合切斷術。由於手術損毀脊髓結構,易引起其他併發症,如運動或感覺障礙,因此,要結合病人的總體機能狀況,慎重選擇。
遠傷病的疼痛,按治療遠傷病的揉摩方法即可,在疼痛部位用藥物揉摩,即可發現遠傷病病灶,此時病人疼痛即會減輕。繼續揉摩,病灶充分現,疼痛會消失,一般 過5-7天再進行一次,通過 二至三次揉摩,病灶不明顯,疼痛也不會再發生。
如果身體極為虛弱的患者,不能承受揉摩時的疼痛,可在表皮上用藥物按摩,以減輕或解除疼痛,但保持不長久。最好在癌症初期,對身體作一次全面的遠傷檢查,凡在身體某部有壓痛的地方,均為遠傷病處,可以先期揉摩,一般通過一、二次揉摩,以後也不會再發生疼痛。
預後預防
 癌性疼痛護理
癌性疼痛護理預後:對於可能治癒的癌症患者,確切有效的止痛可以明顯改善病人的一般情況,使其順利地完成臨床放療、化療等抗腫瘤治療計畫,達到治癒的目的。對於難以治癒的患者,有效的止痛可以使其獲得較為舒適的帶瘤生存,提高其生存質量,並可能延長其生存期。事實上,讓癌症患者無痛或儘量使疼痛減輕到可以耐受的程度是完全能夠做到的。根據WHO公布的資料,單純使用止痛藥物可使90%的疼痛得到不同程度的緩解。
預防:加強對腫瘤的防治,是防止出現癌性疼痛的根本辦法。不僅可增強腫瘤治療效果,提高患者生活質量,延長生存期限,還能期癌症患者在相對無痛的狀態下有尊嚴地走完人生最後旅程。
癌痛食療方
1、青木香橘皮粉
[原料]青木香100克,鮮橘皮100克。
[製法]將青木香、鮮橘皮分別揀雜,洗淨,曬乾或烘乾,青木香切成極薄片並剁碎,鮮橘皮切碎,共研成細末,瓶裝,防潮,備用。
[吃法]每日3次,每次15克,溫開水送服。
[功效]行氣止痛,抗癌解毒。本食療方適用於大腸癌患者腹部脹痛。
2、烏藥蜜飲
[原料]烏藥15克,元胡15克,半枝蓮20克,蜂蜜30克。
[製法]先將烏藥、元胡、半枝蓮分別揀雜,洗淨,晾乾或曬乾,烏藥、元胡切成薄片,半枝蓮切成碎小段,同放入沙鍋,加水浸泡片刻,煎煮20分鐘,用潔淨紗布過濾,去渣,收取濾汁放入容器,調入蜂蜜,拌和均勻即成。
[吃法]早晚2次分服。
[功效]行氣活血,散寒止痛。本食療方適用於大腸癌寒凝氣滯引起的腹部疼痛。
3、大黃紅棗茶
[原料]生大黃6克,紅棗20枚。
[製法]先將生大黃揀雜,洗淨,曬乾或烘乾,切成薄飲片,備用。將紅棗揀雜,淘洗乾淨,放入沙鍋加水足量浸泡片刻,大火煮沸後,改用小火煨煮40分鐘,連同煮沸的大棗煎汁沖泡大黃飲片,或直接將大黃飲片投入大棗煎液中,將沙鍋離火,靜置片刻即成。
[吃法]早晚2次分服,飲湯汁,嚼食大黃飲片及紅棗。
[功效]清熱化濕,緩急止痛。本食療方適用於大腸癌熱積氣滯引起的腹脹、腹痛、大便乾結等症。

